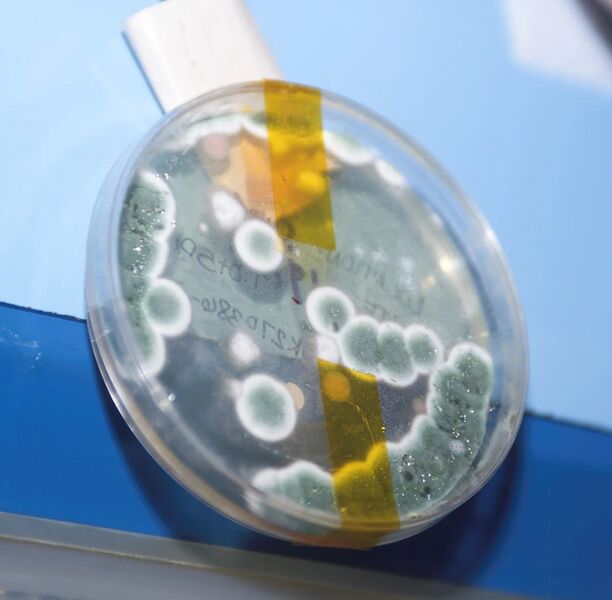

File:Fungus.jpg
File on Bravo Fleet
More actions
Size of this preview: 612 × 600 pixels. Other resolution: 1,863 × 1,825 pixels.
Original file (1,863 × 1,825 pixels, file size: 353 KB, MIME type: image/jpeg)
File history
Click on a date/time to view the file as it appeared at that time.
| Date/Time | Thumbnail | Dimensions | User | Comment | |
|---|---|---|---|---|---|
| current | 10:06, 15 September 2024 |  | 1,863 × 1,825 (353 KB) | Iskander (talk | contribs) | Picture of a fungus. {{Fairuse}} |
You cannot overwrite this file.
File usage
The following page uses this file:

